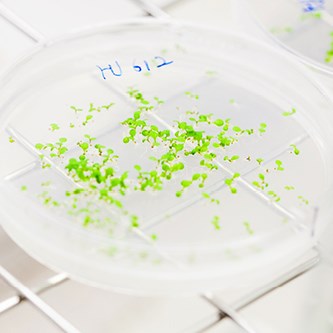

Programme syllabus
Programme Code: SM006
Finalized by: Utbildningsnämnden, 2017-10-17
SLU ID: SLUua2017.3.1.1-3799
Education plan valid from: Autumn 2018
Entry Requirements
Admission to the Master´s (120 credits) programme Plant Biology for Sustainable Production requires
• general entry requirements: a Bachelor´s degree (equivalent to a Swedish kandidatexamen) from an internationally recognised university.
• specific entry requirements: one of the following specialisations at first-cycle level:
90 credits in biology or
60 credits in biology and 30 credits in chemistry or
60 credits in agricultural sciences and 30 credits in biology or
60 credits in horticultural sciences and 30 credits in biology or
60 credits in forest sciences and 30 credits in biology
Applicants with the equivalent qualifications obtained by means of a degree from another country, or with the equivalent knowledge obtained in some other way, may also be regarded as fulfilling the specific entry requirements.
The applicant must further have a level of English equivalent to upper secondary school English 6. An applicant with a first-cycle qualification from SLU comprising 120 credits, or a first-cycle degree from another Swedish university comprising 180 credits, automatically fulfils this requirement. The equivalent qualification may also be obtained in other ways, for more information see universityadmissions.se/antagning.se.
Specific requirements apply for admission to the individual courses included in the programme.
Content
Programme description
The objective of the programme is for students to gain specialised knowledge of plant biology, particularly for sustainable production in agriculture, horticulture and forestry. Plant biology is a central field within biology and covers many different aspects of the life of plants. Plant products are for example of great importance as food, feed, building materials, fibres and pharmaceutical drugs. This means that the knowledge of how plants function, their genetics and interaction with the environment is necessary for sustainable crop production and by extension for sustainable development.
Students who complete the programme are awarded a Master´s (120 credits) degree which can be used for third-cycle studies as well as for work in the industry or in public authorities, with a focus on sustainable solutions for our future society. The programme starts with introductory courses where students obtain basic knowledge of plant biology and molecular genetics as a foundation for other courses. As the programme targets students with different backgrounds, it is important that everyone acquires the basic knowledge that is needed. The introduction also covers general skills such as referencing and sustainable development.
In three courses during the first year, the students gain deepened knowledge of subjects that are of importance to sustainable crop production, providing a progression in the subject. The elective specialisation courses give students the opportunity to deepen their knowledge in an area of plant biology of their choice, e.g. plant protection and plant breeding to handle climate change, plants´ interaction with their surroundings and how they are affected by abiotic and biotic factors, or forestry and how biotechnology and breeding can be used to produce renewable biomaterials from forests.
The programme is taught in English.
The programme has four specialisation tracks, described below.
The specialisations 1-3 are coordinated during the first academic year, and students take basic courses that give a solid foundation in plant biology for continued studies during year 2, as well as providing training in general competences. The students can take these courses in Alnarp, Umeå or Uppsala.
In year 2, students choose one of the specialisations:
Forest Biotechnology (in Umeå)
Plant Protection and Breeding for Mitigating Climate Change (in Alnarp)
Abiotic and Biotic Interactions of Cultivated Plants (in Uppsala)
The specialisations build on the world-leading competence at SLU and supplement one another.
The fourth specialisation, Genetic and Molecular Plant Biology, is a cooperation between SLU, Uppsala University and Stockholm University. The specialisation starts with three basic courses, where each of the three universities is responsible for one course. This means that students take these courses in Uppsala (campuses of SLU and Uppsala University) and Stockholm. The specialisation Genetic and Molecular Plant Biology cannot be combined with the other specialisations.
The students are expected to acquire knowledge of important research, development and methods with respect to plants used for sustainable crop production and thereby be able to work independently with related questions in agriculture and forestry, horticulture, industry, biotechnology and the environment. The skills acquired on the programme include demonstrating the ability to independently, critically and creatively identify and formulate issues that concern the life processes of plants. All qualitative targets are covered during the year 1 basic courses as well as the independent project.
The programme is intended for national as well as international students who want to deepen their knowledge in plant biology in one of the four elective specialisations. The programme is taught entirely in English. The teaching on this programme is strongly geared towards preparing students for research, and all specialisations on the programme have links to strong research environments. It may also lead to professions in several land-based sectors, especially the specialisations in forest biotechnology and plant protection and plant breeding.
Courses in the programme
Specialisations
Forest Biotechnology
Plant Protection and Plant Breeding
Abiotic and Biotic Interactions of Cultivated Plants
Year 1 (preliminary course titles)
Introduction to Plant Biology for Sustainable Production, 15 credits, A1N
Growth and Development of Plants, 15 credits, A1N
Plant Breeding and Plant Protection, 15 credits, A1N
Sustainable Crop Production from Molecular to Stand Level, 15 credits, A1N
Elective courses year 2
Campus Umeå
Biology and Biotechnology for Forestry Production Systems, 15 credits, A1N
Bioenergy and Biomaterials, 15 credits, A1F
Campus Alnarp
Integrated Plant Protection Strategies for Sustainable Cropping Systems, 15 credits, A1N
Advanced Plant Breeding and Genetic Resources, 15 credits, A1F
Campus Ultuna
Experimental Approaches in Plant Growth Analysis and Phenotyping, 15 credits, A1N
Molecular Plant-Microbe Interactions, 15 credits, A1F
Specialisation
- Genetic and Molecular Plant Biology
Year 1
Genetic and Molecular Plant Science, Uppsala University, 15 credits, A1N
Genetic Diversity and Plant Breeding, SLU, 15 credits, A1N
Molecular Plant-Microbe Interactions, Stockholm University, 15 credits, A1N
Sustainable Crop Production from Molecular to Stand Level, SLU, 15 credits, A1N
Elective courses year 2
Functional Genomics, Uppsala University, 15 credits, A1N
Plant Pathology, SLU, 15 credits, A1N
Research placement, SLU, 15 credits, A1F
In all specialisations, an independent project of 30 or 60 credits in the main field biology (A2E) is included according to the approved study plan.
The courses offered may change during the course of the programme. Decisions on the courses offered are taken well in advance of the next academic year.
For each course, there is a course syllabus providing more detailed course information. Information on when courses are offered is available on the SLU student web.
Objectives
General objectives
The general objectives for first- and second-cycle courses and programmes are specified in the Swedish Higher Education Act (Chapter 1, Sections 8–9).
Objectives for a Degree
In accordance with the annex to the Ordinance for the Swedish University of Agricultural Sciences, for a degree of Master (120 credits) the student shall:
Knowledge and understanding
For a degree of Master (120 credits), the student shall
demonstrate knowledge and understanding in the main field of study, including both broad knowledge of the field and a considerable degree of specialised knowledge in certain areas of the field as well as insight into current research and development work, and
demonstrate specialised methodological knowledge in the main field of study.
Competence and skills
For a degree of Master (120 credits), the student shall
demonstrate the ability to critically and systematically integrate knowledge and analyse, assess and deal with complex phenomena, issues and situations even with limited information
demonstrate the ability to identify and formulate issues critically, autonomously and creatively as well as to plan and, using appropriate methods, undertake advanced tasks within predetermined time frames and so contribute to the formation of knowledge as well as the ability to evaluate this work
demonstrate the ability in speech and writing both nationally and internationally to clearly report and discuss his or her conclusions and the knowledge and arguments on which they are based in dialogue with different audiences, and
demonstrate the skills required for participation in research and development work or autonomous employment in some other qualified capacity.
Judgement and approach
For a degree of Master (120 credits), the student shall
demonstrate the ability to make assessments in the main field of study informed by relevant disciplinary, social and ethical issues and also to demonstrate awareness of ethical aspects of research and development work
demonstrate insight into the possibilities and limitations of research, its role in society and the responsibility of the individual for how it is used, and
demonstrate the ability to identify the personal need for further knowledge and take responsibility for his or her ongoing learning.
Qualification Requirements
Degree awarded on completion of the programme
Upon completion of the programme, the degree of Master of Science (120 credits) with a major in biology is awarded. Other general qualifications may be awarded, provided that the requirements are fulfilled. More information can be found in SLU´s degree regulations.
Students who fulfil the qualification requirements for a degree will be issued a degree certificate upon request. The degree certificate will specify the qualification as Degree of Master of Science (120 credits) with a Major in Biology (masterexamen med huvudområdet biologi).
Degree requirements
A degree of Master of Science (120 credits) with a major in biology is awarded to students who fulfil the course requirements (courses with a Pass grade) of 120 credits, according to the following
- at least 30 credits of courses with specialised study in the main field (A1N; A1F),
- at least 30 credits from an independent project (degree project) in the main field biology (A2E).
A maximum of 30 credits may be from courses at first-cycle level.
In addition, the student must hold a degree of Bachelor, a professional qualification of at least 180 credits or an equivalent qualification.
Transitional Provisions
Students admitted to SM006 before the 2023 autumn semester are entitled to complete their studies leading to a Master's degree with a major in biology, which is a general degree. They may complete their studies according to this syllabus until 30 June 2026. Courses listed in the programme syllabus will be gradually phased out; some may already have been discontinued or replaced by other courses. If needed, an individual study plan will be drawn up. Students can also be assessed to determine if they can complete their studies within the latter part of the LM011 degree programme. Places will be allocated according to the current rules for resuming studies.
Other Regulations
The courses during year for specialisation 4, Genetic and Molecular Plant Biology, cannot be combined with the courses for specialisation 1-3 for a degree as the content of these courses overlaps.
The programme is offered jointly by SLU departments in Alnarp, Umeå and Uppsala and is a national (Stockholm University, Umeå University and Uppsala University) and international cooperation (University of Helsinki).
This syllabi is up dated, due to a general decision in the University board for Education (UN), regarding the maximum of basic level credits that can be included in a master degree. Before only 15 credits in basic level where possible to include, after decision in fall 2018, up to 30 credits in basic level can be included.
OtherInformation
General regulations for first- and second-cycle courses and programmes
For more information on semester dates, examination and credit transfer, see the Regulations for education at Bachelor´s and Master´s level available on the SLU student web.
Possibilities for further studies
the programme Plant Biology for Sustainable Production and are awarded a degree of Master (120 credits) have the option to continue their studies at doctoral level.